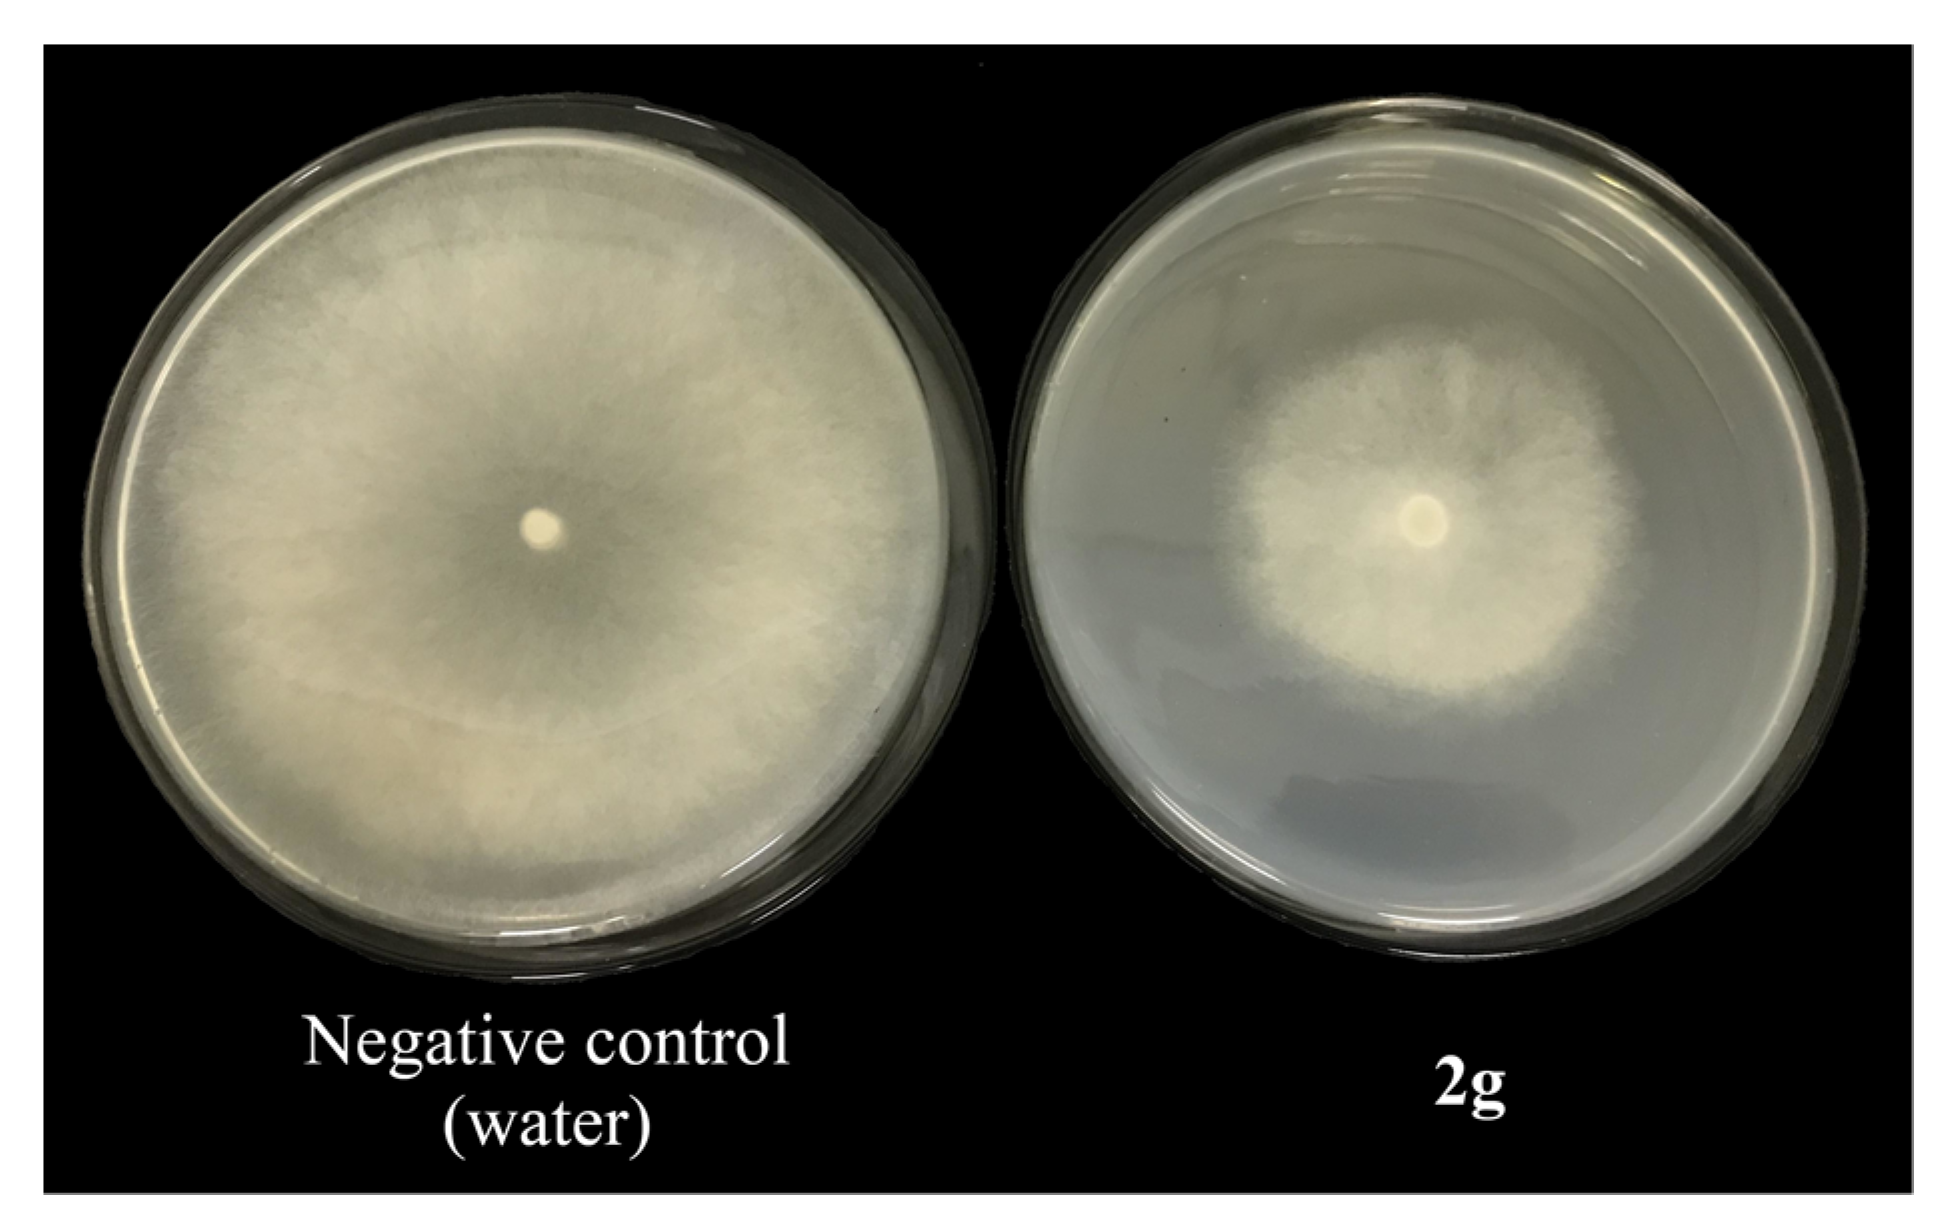
Molecules 28 00419 g003 Molecules 28 00419 g003

Abstract
The addition of active groups of known fungicides, or systemic acquired resistance inducers, into novel compound molecules to search for potential antifungal compounds is a popular and effective strategy. In this work, a new series of N-acyl-N-arylalanines was developed and synthesized, in which 1,2,3-thiadiazol-5-ylcarbonyl or 3,4-dichloroisothiazol-5-ylcarbonyl (fragments from synthetic plant resistance activators tiadinil and isotianil, respectively) and a fragment of N-arylalanine, the toxophoric group of acylalanine fungicides. Several new synthesized compounds have shown moderate antifungal activity against fungi in vitro, such as B. cinerea, R. solani and S. sclerotiorum. In vivo tests against A. brassicicola showed that compound 1d was 92% effective at a concentration of 200 µg/mL, similar to level of tiadinil, a known inducer of systemic resistance. Thus, 1d could be considered a new candidate fungicide for further detailed study. The present results will advance research and influence the search for more promising fungicides for disease control in agriculture.
1. Introduction
Phytopathogenic fungi are the key pathogens of plant diseases and lead to significant losses in agricultural crops [1,2]. The search for new molecules showing fungicidal activity for the development of plant protection products is a topical area of organic chemistry.
Acylalanine derivatives are a promising class of compounds in the search for new molecules with high fungicidal activity. When such systematic fungicides as furalaxyl, metalaxyl and benalaxyl appeared on the agricultural market in the late 1970s, they showed very good protective properties against oomycetes, especially Peronosporales, such as Phytophthora spp., Pseudoperonospora spp., Peronospora spp., Plasmopara spp., Pythium spp. It was established, on the example of fungi belonging to Peronosporales, that the main mechanism of action of this class of fungicides was specific inhibition of RNA polymerase-1 and blocking of rRNA synthesis [3]. Fungicides of the acylalanine class contain a chiral carbon atom in their alkyl moiety, and the activity of the enantiomers is often different. Accordingly, metalaxyl is a mixture of two enantiomers; however, the fungicidal activity of metalaxyl is almost completely due to its R-enantiomer [3]. Many countries use metalaxyl-M instead of racemic metalaxyl to protect agricultural plants, which consists of 97.5% active (R)-enantiomer and 2.5% (S)-enantiomer as an impurity [4]. The fungicide benalaxyl is a racemic mixture of enantiomers, but both enantiomers are responsible for its fungicidal activity, although R-benalaxyl has a higher fungicidal activity and is more toxic to the environment [5].
The uncontrolled use of acylalanine fungicides without alternation with other antifungal agents has caused the spread of resistant strains of phytopathogens [6]. Currently, acylalanine fungicides are used in combination with other pesticides [7]. Of late, this approach in plant protection has seen use everywhere, with the use of combined pesticides becoming increasingly frequent in agriculture.
One modern direction in the protection of plants from microbial infections is the use of compounds capable of inducing the natural defense mechanisms of plants against virulent pathogens [8]. Induced resistance is a transient phenotypic resistance based on the expression of multiple defense genes and is therefore non-specific. It allows plants to be protected from various types of pathogens, including fungi, bacteria and viruses. However, the effectiveness of induced plant resistance may not be the same in relation to different types of pathogenic microorganisms, since some pathogens do not respond to the use of certain resistance inducers. In some cases, increased plant damage was observed. A similar phenomenon was noted, for example, in relation to fungi from the genera Fusarium (F. oxysporum, F. solani), Rhizoctonia, Botritys cinerea and Phaeoisariopsis personata [9,10].
One approaches in the search for promising new molecules for plant protection is the combination, in one molecule, of structural fragments from lead compounds with different biological mechanisms of action [11]. The introduction of such fragments into the structure of the molecule increases the chances of discovering substances with potent biological activity. Additionally, this approach has been implemented to search for compounds with a double mode of action. Thus, combining fragments of antifungal compounds and inducers of plant defense systems in one compound is a potentially valuable strategy for seeking pesticides for complex plant protection.
This strategy was successful when fragments of the known synthetic plant resistance inducer isotianil and fungicides with sinnamic acid derivatives, such as dimethomorph, flumorph and pyrimorph, were combined in new substances [12]. The combinations led to disruption of cell wall biosynthesis and oxathiapiprolin—a piperidinyl thiazole isoxazoline fungicide targeting at oxysterol binding protein [13] (Scheme 1).
Scheme 1.
Design strategy of previously synthesized fungicidal compounds.
The aim of this study was the synthesis of combined molecules 1 and 2 (Scheme 2) containing 1,2,3-thiadiazol-5-ylcarbonyl or 3,4-dichloroisothiazol-5-ylcarbonyl fragments, respectively (residues of synthetic plant resistance activators tiadinil and isotianil), as well as a fragment of N-arylalanine (the toxophoric group of acylalanine fungicides) (Scheme 2).
Scheme 2.
Design strategy of the target compounds.
The design of the target molecules was realized on the basis of the common acylanilide moiety, which is present both in the acylalanine fungicides and in the SAR inducers tiadinil and isotianil.
2. Results and Discussion
2.1. Synthesis of Target Compounds
Starting aromatic amines 3a–l were obtained by N-alkylation of various anilines 4a–l with methyl-(RS)-2-chloropropionate 5 in ethanol in addition of sodium acetate [14,15,16], but the yields were very low. The reaction of aniline with chloropropionate was used as a model reaction to select conditions to increase the reaction yield. The reactions were carried out under previously published conditions for the N-alkylation of aromatic amines with alkyl chlorides: in acetonitrile in the presence of potassium carbonate or sodium carbonate [17,18,19,20] and in DMF with potassium carbonate [21,22]. It was found that the highest yield was achieved when the reaction was carried out in DMF in the presence of potassium carbonate. Furthermore, Finkelstein reaction conditions [23] were used, in which the alkylating agent was activated by in situ formation of alkyl iodide when potassium iodide was added to the reaction mixture. The addition of 1.0 equivalents of potassium iodide increased the yield from 50 to 71% and the addition of 2 equivalents of potassium iodide to the reaction mixture increased the reaction yield to 92% (Table 1).
Table 1.
Optimization of reaction for synthesis of compound 3a.
Target compounds 1a–l and 2a–l were synthesized by N-acylation of disubstituted amines 3a–l with 4-methyl-1,2,3-thiadiazol-5-ylcarboxylic acid chloride 6a or 3,4-dichloroisothiazol-5-ylcarboxylic acid chloride 6b, respectively, in the presence of triethylamine in dry benzene (Table 2). Dry tetrahydrofuran was also used as a solvent, but the reaction yields were much lower.
Table 2.
Synthesis route of the target compounds 1a–l and 2a–l.
2.2. Structural Analysis
All the corresponding signals of protons and carbons were recorded in the 1H and 13C NMR spectra of the obtained compounds. However, for compounds 1i and 2i, the 1H NMR spectra contained a double set of signals for all protons except for the protons of methyl groups in the ortho-positions of the aryl substituent and the methyl group in position 4 of the 1,2,3-thiadiazole ring for compound 1i. It was observed, from the integrated intensity, that the signals of the protons of the minor isomer of methyl-N-acyl-N-arylalaninates 1i and 2i coincided with the signals of the major isomer. The ratio of isomers, according to 1H NMR spectra, was approximately 1:3–1:5. In the 13C NMR spectra of compounds 1i and 2i, a double set of signals of all carbons as also observed, except for the signal of the carbon of the aryl substituent bound to the nitrogen atom of the amide group at 138.8 ppm for 1,2,3-thiadiazole derivative 1i. The likelihood was that the formation of diastereoisomer pairs was associated with the formation of the second asymmetric center due to hindered rotation of the ortho-substituted asymmetric aryl fragment of the molecule relative to the C–N σ-bond.
The compound 1f crystallized in the orthorhombic space group Pbca. In this case, the N(4) atom had a trigonal pyramidal configuration. The tertiary amine nitrogen atom N(1) had a planar configuration, as the sum of valency angles was 359.4° (Figure 1). The C-N bond lengths of the trisubstituted amine moiety were 1.483(5) Å, 1.434(5) Å, and 1.362(5) Å for C(2)-N(1), C(7)-N(1) and C(6)-N(1), respectively, and corresponded to the lengths of C-Alk, C-Ar and C-N (amide) bonds, respectively, in published crystal structures [24,25,26,27,28,29,30,31,32,33,34,35,36,37]. The N(1), C(2), C(1), and O(2) atoms were in the same plane, with an RMSD of 0.038 Å. The angle between the RMS planes of N(1)C(2)C(1)O(2) and the thiadiazole ring was 51.93°, while the angle between the RMS planes of N(1)C(2)C(1)O(2) and the benzene ring was 122.98°.
Figure 1.
The molecular structure of the compound 1f, showing the atom numbering scheme for the non-H atoms. Displacement ellipsoids are drawn at the 50% probability level.
The crystal structure contained molecules of two enantiomers. In enantiomeric pairs, the formation of a C(13)H(13)C…O(2) contacts with the following interaction parameters were observed: d(H(13C)…O(2)) = 2.478(3) Å, ∠C(13)H(13C)…O(2) = 157.7(3)° and symmetry operation i) 1/2 + x, +y, 3/2 − z. In the crystal structure between the molecules of the (S-) or (R-) configuration, there also occurred C(2)H(2)…Cl(1) contacts with the following interaction parameters: d(H(2)…Cl(1)) = 2.91(5) Å, ∠C(2)H(2)…Cl(1) = 133(3)° and symmetry operation i) 1 + x, 2 + y, +z. Contacts C(13)H(13C)…O(2) and C(2)H(2)…Cl(1) held enantiomeric pairs together in a double chain in the direction of the a-axis (Figure 2).
Figure 2.
Part of the crystal lattice of compound 1f, showing the formation of a double chain along the a-axis with C(2)H(2)…Cl(1) and C(13)H(13C)…O(2) bonds. For clarity, only those hydrogen atoms which are engaged in the intermolecular interactions are indicated. Symmetry codes: (i) 1/2 + x, +y, 3/2 − z (ii) 1 + x, 2 + y, +z (iii) 3/2 + x, +y, 3/2 − z.
2.3. Fungicidal Activity In Vitro
The fungicidal activity of the target compounds was studied in vitro, according to a previously published method [38], against the oomycete Phytophthora infestans (P.i.) and the following phytopathogenic fungi: Alternaria solani (A.s.), Alternaria brassicicola (A.b.), Botrytis cinerea (B.c.), Colletotrichum coccodes (C.c.), Fusarium solani (F.s.), Plenodomus lingam (P.l.), Rhizoctonia solani (R.s.) and Sclerotinia sclerotiorum (S.s.). The fungicidal properties of N-acyl-N-arylalaninate derivatives were studied at a concentration of 100 μg/mL. The commercial fungicide carbendazim was used as a positive control. The obtained data of fungicidal activity for the studied compounds are shown in Table 3.
Table 3.
Degree of fungal growth inhibition for compounds 1a–l and 2a–l at a concentration of 100 μg/mL (bold font indicates medium degrees of inhibition) *.
Compounds with moderate fungicidal activity were identified in the series of 3,4-dichloroisothiazole derivatives. Thus, compounds 2a and 2g inhibited the radial growth of B. cinerea, R. solani and S. sclerotiorum by more than 60% (Figure 3). Compounds 1h and 2h, containing a 3,5-dichloroaryl substituent in their structure, also exhibited moderate fungicidal activity against S. sclerotiorum. It should be noted that 3,4-dichloroisothiazole derivatives were more effective compared to 1,2,3-thiadiazole derivatives containing similar aryl substituents.
Figure 3.
Growth inhibition of S. sclerotiorum in addition of compound 2g to the medium at a concentration of 0.1 mg/mL.
2.4. Fungicidal and Protective Properties In Vivo
The fungicidal and protective properties of two derivatives of N-acyl-N-arylalaninates, at a concentration of 200 μg/mL, were studied in vivo on rapeseed leaves. Compounds 1d and 2d were chosen for the experiment. They contained, in their structure, a 2,6-dimethylphenyl substituent, which is also contained in the structure of fungicides such as metalaxyl and furalaxyl. Two synthetic systemic resistance inducers in plants, tiadinil and isotianil, were used as reference substances. Compound 1d, containing a 1,2,3-thiadiazole ring in its structure, was shown to completely inhibit leaf damage and prevent the formation of necrotic spots (Table 4, Figure 4). At the same time, the protective properties of compound 1d turned out to be higher than those of tiadinil. Compound 2d, at the studied concentration, almost entirely failed to inhibit leaf damage, just like isotianil, another commercial inducer of plant SAR.
Table 4.
In vivo efficacy of compounds on rape leaves infected by A. brassicicola.
Figure 4.
Effects of compound 1d and 2d against A. brassicicola-infected rape leaves.
Since it was shown in vitro that the 1,2,3-thiadiazole derivative 1d exhibited very weak fungicidal activity against A. brassicicola (I = 12.05 ± 0.08%), it could be assumed that compound 1d either stimulated the protective properties of rapeseed plants or became more active in vivo.
Thus, we showed the study of the obtained substances 1a–l, 2a–l in vivo, as well as the expansion of their range, to be a promising direction for the search for new substances for plant protection, despite the low fungicidal activity in vitro. The study of the mechanism and spectrum of biological action of compound 1d would be equally enticing.
3. Materials and Methods
3.1. Chemical Synthesis
1H and 13C NMR spectra were recorded with a Bruker Avance II (Karlsruhe, Germany) spectrometer (400 MHz for 1H, 100 MHz for 13C). The NMR spectra of all compounds are demonstrated in the Supporting Information (Figures S1–S53). Mass spectra were recorded with a Shimadzu GCMS-QP 2010 “Ultra” (Kyoto, Japan) in electron ionization (EI) mode (electron energy 70 eV). The Fourier transform infrared (FT-IR) spectra were obtained using a Bruker Alpha (ATR, ZnSe) spectrometer (Ettlingen, Germany). Elemental analyses were performed with a Perkin-Elmer 2400Series II CHNS/O analyzer (Shelton, CT USA). Melting points were determined using a Stuart SMP 3 apparatus (Staffordshire, ST15 OSA, UK). The progress of the reactions and the purity of the compounds were monitored by TLC on TLC Silica gel 60 F245 aluminum sheets (Merck KGaA) in an EtOAc-hexane system (1:9 or 1:5).
3.1.1. General Procedure for Preparation of Methyl N-aryl-(RS)-alaninates (3a–l)
Aniline derivatives (10.0 mmol) were dissolved in 15 mL of dry DMF. Then, 1.0 eq. of potassium carbonate and 2.0 eq. of potassium iodide were added and 12.0 mmol of methyl-(RS)-2-chloropropionate was added dropwise. The reaction mixture was heated with stirring to 80 °C for 16–20 h. The precipitate was filtered off and washed with DMF. The filtrate was then poured into 100 mL of water and extracted with ethyl acetate (3 × 100 mL). The combined organic fractions were washed with water (3 × 100 mL) and 1N HCl (2 × 100 mL), and dried over anhydrous Na2SO4. Thereafter, the solvent was distilled off. Purification was carried out using column chromatography; eluent was ethyl acetate/hexane 1:5 or 1:9. The solvent was distilled off from the combined fractions after elution without pre-drying.
Methyl N-phenyl-(RS)-alaninate (3a) [39]. Yellow oil, yield 1.649 g (92%). 1H NMR (400 MHz, DMSO-d6) δ 7.07 (dd, J = 7.6, 8.1 Hz, 2H, CH Ar), 6.58–6.52 (m, 3H, CH Ar), 5.95 (d, J = 8.2 Hz, 1H, NH), 4.10–4.02 (m, 1H, CH), 3.62 (s, 3H, OCH3), 1.36 (d, J = 7.0 Hz, 3H, CH3); EI-MS m/z (%): 179 [M]+ (11), 120 (100), 104 (5), 91 (4), 77 (15).
Methyl N-(m-tolyl)-(RS)-alaninate (3b). Yellow oil, yield 1.469 g (76%). 1H NMR (400 MHz, DMSO-d6) δ 6.94 (dd, J = 7.7, 7.7 Hz, 1H, CH Ar), 6.39–6.31 (m, 3H, CH Ar), 5.85 (d, J = 7.7 Hz, 1H, NH), 4.08–4.01 (m, 1H, CH), 3.62 (s, 3H, OCH3), 2.17 (s, 3H, CH3), 1.36 (d, J = 7.0 Hz, 3H, CH3); EI-MS m/z (%): 194 [M+1]+ (2), 193 [M]+ (14), 134 (100), 132 (5), 119 (12), 118 (11), 91 (18), 77 (5).
Methyl N-(p-tolyl)-(RS)-alaninate (3c). Yellow oil, yield 1.527 g (79%). 1H NMR (400 MHz, DMSO-d6) δ 6.88 (d, J = 8.2 Hz, 2H, CH Ar), 6.45 (d, J = 8.2 Hz, 2H, CH Ar), 5.73 (d, J = 8.5 Hz, 1H, NH), 4.06–3.98 (m, 1H, CH), 3.61 (s, 3H, OCH3), 2.14 (s, 3H, CH3), 1.36 (d, J = 7.0 Hz, 3H, CH3); EI-MS m/z (%): 193 [M]+ (13), 134 (100), 118 (11), 91 (15), 77 (5).
Methyl N-(2,6-dimethylphenyl)-(RS)-alaninate (3d) [39]. Yellow oil, yield 1.824 g (88%). 1H NMR (400 MHz, DMSO-d6) δ 6.92 (d, J = 7.4 Hz, 2H, CH Ar), 6.73 (t, J = 7.4 Hz, 1H, CH Ar), 4.11 (d, J = 11 Hz, 1H, NH), 3.91–3.83 (m, 1H, CH), 3.57 (s, 3H, OCH3), 2.22 (s, 6H, 2CH3), 1.34 (d, J = 6.9 Hz, 3H, CH3); EI-MS m/z (%): 207 [M]+ (16), 148 (100), 132 (10), 105 (10), 77 (13).
Methyl N-(2,4,6-trimethylphenyl)-(RS)-alaninate (3e) [40]. Orange oil, yield 1.284 g (58%). 1H NMR (400 MHz, DMSO-d6) δ 6.72 (s, 2H, CH Ar), 3.97 (d, J = 6.9 Hz, 1H, NH), 3.83–3.74 (m, 1H, CH), 3.58 (s, 3H, OCH3), 2.18 (s, 6H, 2CH3), 2.13 (s, 3H, CH3), 1.31 (d, J = 6.9 Hz, 3H, CH3); EI-MS m/z (%): 221 [M]+ (3), 176 (2), 162 (100), 146 (7), 132 (8), 119 (7), 103 (3), 91 (13), 77 (7).
Methyl N-(3-chlorolphenyl)-(RS)-alaninate (3f) [41]. Dark yellow oil, yield 1.624 g (76%). 1H NMR (400 MHz, DMSO-d6) δ 7.07 (dd, J = 8.2, 8.3 Hz, 1H, CH Ar), 6.57–6.55 (m, 2H, CH Ar), 6.49 (d, J = 7.7 Hz, 1H, CH Ar), 6.32 (d, J = 8.1 Hz, 1H, NH), 4.14–4.07 (m, 1H, CH), 3.63 (s, 3H, OCH3), 1.37 (d, J = 6.9 Hz, 3H, CH3); EI-MS m/z (%): 215 [M+2]+ (5), 213 [M]+ (15), 156 (32), 154 (100), 153 (5), 138 (5), 119 (13), 118 (17), 111 (8), 99 (2), 91 (6), 77 (5), 75 (10).
Methyl N-(4-chlorolphenyl)-(RS)-alaninate (3g) [39]. Light yellow oil, yield 1.667 g (78%). 1H NMR (400 MHz, DMSO-d6) δ 7.09 (d, J = 8.8 Hz, 2H, CH Ar), 6.55 (d, J = 8.8 Hz, 2H, CH Ar), 6.17 (d, J = 8.2 Hz, 1H, NH), 4.10–4.03 (m, 1H, CH), 3.62 (s, 3H, OCH3), 1.37 (d, J = 7.0 Hz, 3H, CH3). EI-MS m/z (%): 215 [M+2]+ (4), 213 [M]+ (13), 156 (32), 154 (100), 138 (6), 119 (29), 118 (22), 111 (9), 99 (4), 91 (7).
Methyl N-(3,5-dichlorolphenyl)-(RS)-alaninate (3h). Light brown oil, yield 1.319 g (53%). 1H NMR (400 MHz, DMSO-d6) δ 6.65 (d, J = 1.7 Hz, 1H, CH Ar), 6.62 (d, J = 8.2 Hz, 1H, NH), 6.56 (d, J = 1.7 Hz, 2H, CH Ar), 4.18 (p, J = 7.0 Hz, 1H, CH), 3.65 (s, 3H, OCH3), 1.36 (d, J = 7.0 Hz, 3H, CH3); EI-MS m/z (%): 251 [M+4]+ (2), 249 [M+2]+ (10), 247 [M]+ (17), 192 (10), 190 (64), 188 (100), 155 (6), 153 (19), 152 (11), 138 (3), 117 (12), 91 (4).
Methyl N-(2-methyl-3-chlorolphenyl)-(RS)-alaninate (3i). Yellow oil, yield 1.662 g (73%). 1H NMR (400 MHz, DMSO-d6) δ 6.98 (dd, J = 7.9, 8.2 Hz, 1H, CH Ar), 6.70 (d, J = 7.9 Hz, 1H, CH Ar), 6.37 (d, J = 8.2 Hz, 1H, CH Ar), 5.27 (d, J = 8.1 Hz, 1H, NH), 4.20–4.10 (m, 1H, CH), 3.64 (s, 3H, OCH3), 2.21 (s, 3H, CH3), 1.46 (d, J = 7.0 Hz, 3H, CH3); EI-MS m/z (%): 229 [M+2]+ (6), 227 [M]+ (18), 170 (33), 168 (100), 152 (6), 132 (8), 118 (16), 117 (15), 104 (3), 89 (14), 77 (8).
Methyl N-(3-methoxyphenyl)-(RS)-alaninate (3j) [42]. Orange oil, yield 1.548 g (74%). 1H NMR (400 MHz, DMSO-d6) δ 6.97 (dd, J = 8.1, 8.1 Hz, 1H, CH Ar), 6.17–6.10 (m, 3H, CH Ar), 5.99 (d, J = 8.2 Hz, 1H, NH), 4.08–4.01 (m, 1H, CH), 3.66 (s, 3H, OCH3), 3.63 (s, 3H, OCH3), 1.36 (d, J = 7.0 Hz, 3H, CH3); EI-MS m/z (%): 209 [M]+ (15), 150 (100), 135 (12), 134 (6), 118 (4), 107 (11), 92 (9), 77 (11).
Methyl N-(4-methoxyphenyl)-(RS)-alaninate (3k) [43]. Yellow oil, yield 1.276 g (61%). 1H NMR (400 MHz, DMSO-d6) δ 6.70 (d, J = 8.8 Hz, 2H, CH Ar), 6.50 (d, J = 8.8 Hz, 2H, CH Ar), 5.54 (d, J = 8.8. Hz, 1H, NH), 4.03–3.95 (m, 1H, CH), 3.63 (s, 3H, OCH3), 3.60 (s, 3H, OCH3), 1.34 (d, J = 7.0 Hz, 3H, CH3); EI-MS m/z (%): 209 [M]+ (18), 150 (100), 135 (12), 134 (12), 122 (4), 119 (5), 118 (4), 108 (5), 107 (7), 106 (6), 92 (5), 80 (5), 77 (7).
Methyl 3-trifluoromethylphenyl-(RS)-alaninate (3l) [39]. Light brown oil, yield 2.200 g (89%). 1H NMR (400 MHz, DMSO-d6) δ 7.28 (dd, J = 7.7, 7.8 Hz, 1H, CH Ar), 6.86–6.77 (m, 3H, CH Ar), 6.50 (d, J = 8.1 Hz, 1H, NH), 4.21–4.14 (m, 1H, CH), 3.63 (s, 3H, CH3), 1.39 (d, J = 7.0 Hz, 3H, CH3); EI-MS m/z (%): 248 [M+1]+ (2), 247 [M]+ (14), 228 (4), 189 (11), 188 (100), 172 (4), 148 (3), 145 (11), 119 (8), 118 (6), 95 (4).
3.1.2. General Procedure for Preparation Methyl N-(Heteryl-5-carbonyl)-N-aryl-(RS)-alaninates (1a–l and 2a–l)
Briefly, 4-Methyl-1,2,3-thiadiazol-5-ylcarboxylic acid chloride, or 3,4-dichloroisothiazolylcarboxylic acid chloride (1.5 mmol), was added dropwise to methyl aryl-(RS)-alaninate (1.0 mmol) in 10 mL of dry tetrahydrofuran. While cooling, triethylamine 1.5 mmol was added. The reaction mixture was stirred at 50 °C for 4 h. Water was added and the resultant extracted with ethyl acetate (3 × 25 mL). The combined organic layers were washed with brine, 1N hydrochloric acid, saturated soda and water, then dried under anhydrous sodium sulfate. Ethyl acetate was distilled off under reduced pressure. Purification of the resulting product was carried out using column chromatography with ethyl acetate–hexane 1:9 or 1:5 as eluents. The solvent was distilled off from the combined fractions after elution without pre-drying.
Methyl-N-(4-methyl-1,2,3-thiadiazole-5-carbonyl)-N-phenyl-(RS)-alaninate (1a): yellow oil, yield 0.223 g (73%); IR, ν, cm−1: 2998, 2951, 1745 (C=O), 1635 (C=O), 1486, 1455, 1455, 1382, 1347, 1260, 1200, 1112, 1049,1021, 981; 1H NMR (400 MHz, DMSO-d6) δ 7.38 (s, 5H, H Ar), 5.03 (q, J = 7.2 Hz, 1H, CH), 3.74 (s, 3H, OCH3), 2.67 (s, 3H, HetCH3), 1.33 (d, J = 7.2 Hz, 3H, CH3); 13C NMR (100 MHz, DMSO-d6) δ 171.2 (C=O), 160.4 (C=O), 159.3 (C Het), 142.3 (C Het), 138.8 (C Ar), 129.6 (CH Ar), 129.5 (CH Ar), 129.4 (CH Ar), 56.4 (CH), 52.3 (OCH3), 14.8 (CH3), 13.1 (CH3 Het); EI-MS m/z (%): 305 [M]+ (1), 274 [M–CH3O]+ (2), 245 [M–HCO2CH3]+ (12), 218 [M–CH(CH3)CO2CH3]+ (39), 178 [M–HetCO]+ (42), 99 [HetCO–N2]+ (100). Analysis calculated for C14H15N3O3S (Mr = 305.35): C 55.07, H 4.95, N 13.76, S 10.50; found: C 54.90, H 5.06, N 13.48, S 10.25%.
Methyl-N-(4-methyl-1,2,3-thiadiazole-5-carbonyl)-N-(m-tolyl)-(RS)-alaninate (1b): beige powder, yield 0.236 g (74%); m.p. 82–83 °C; IR, ν, cm−1: 2994, 2954, 1744 (C=O), 1636 (C=O), 1601, 1485, 1455, 1381, 1367, 1348, 1272, 1244, 1208, 1193, 1179, 1110, 1051, 1016, 977; 1H NMR (400 MHz, DMSO-d6) δ 7.29–7.13 (m, 4H, H Ar), 4.97 (q, J = 7.1 Hz, 1H, CH), 3.74 (s, 3H, OCH3), 2.67 (s, 3H, CH3), 2.27 (s, 3H, CH3), 1.33 (d, J = 7.1 Hz, 3H, CH3); 13C NMR (100 MHz, DMSO-d6) δ 171.2 (C=O), 160.3 (C=O), 159.6 (C Het), 142.2 (C Het), 139.5 (CH Ar), 138.8, 130.1, 129.8, 129.5 (CH Ar), 126.5 (C Ar), 56.6 (CH), 52.3 (OCH3), 20.7 (CH3), 14.8 (CH3), 13.2 (CH3); EI-MS m/z (%): 319 [M]+ (2), 290 (3), 288 [M–OCH3]+ (2), 259 [M–HCO2CH3]+ (10), 232 [M–CH(CH3)CO2CH3]+ (26), 192 [M–HetCO]+ (40), 148 (12), 132 (19), 118 (36), 99 [HetCO–N2]+· (100). Analysis calculated for C15H17N3O3S (Mr = 319.38): C 56.41, H 5.37, N 13.16, S 10.04; found: C 56.26, H 5.25, N 12.87, S 10.15%.
Methyl-N-(4-methyl-1,2,3-thiadiazole-5-carbonyl)-N-(p-tolyl)-(RS)-alaninate (1c): light yellow oil, yield 0.217 g (68%); IR, ν, cm−1: 2992, 2951, 1743 (C=O), 1642 (C=O), 1605, 1578, 1510, 1452, 1382, 1331, 1275, 1207, 1151, 1110, 1088, 1046, 1017, 978; 1H NMR (400 MHz, DMSO-d6) δ 7.24 (d, 2H, J = 8.2 Hz, H Ar), 7.20 (d, 2H, J = 8.2 Hz, H Ar), 5.01 (q, 1H, J = 7.3 Hz, CH), 3.73 (s, 3H, OCH3), 2.67 (s, 3H, HetCH3), 2.28 (s, 3H, CH3), 1.30 (d, 3H, J = 7.3 Hz, CH3); 13C NMR (100 MHz, DMSO-d6) δ 171.3 (C=O), 160.5 (C=O), 159.5 (C Het), 142.3 (C Het), 139.2 (C Ar), 136.1 (C Ar), 130.1 (C Ar), 129.3 (C Ar), 56.2 (CH), 52.3 (OCH3), 20.6 (CH3), 14.8 (CH3), 13.1 (CH3); EI-MS m/z (%): 319 [M]+ (5), 288 [M–OCH3]+ (2), 259 [M–HCO2CH3]+ (9), 232 [M–CH(CH3)CO2CH3]+ (36), 192 [M–HetCO]+ (42), 99 [HetCO–N2]+ (100). Analysis calculated for C15H17N3O3S (Mr = 319.38): C 56.41, H 5.37, N 13.16, S 10.04; found: C 56.33, H 5.13, N 13.21, S 9.87%.
Methyl-N-(4-methyl-1,2,3-thiadiazole-5-carbonyl)-N-(2,6-dimethylphenyl)-(RS)-alaninate (1d): white powder, yield 0.230 g (69%); m.p. 127–128 °C; IR, ν, cm−1: 2996, 2948, 1743 (C=O), 1636 (C=O), 1462, 1394, 1355, 1322, 1269, 1243, 1201, 1151, 1121, 1099, 1012, 974; 1H NMR (400 MHz, DMSO-d6) δ 7.37 (t, J = 7.5 Hz, 1H, H Ar), 7.26–7.22 (m, 2H, H Ar), 4.66 (q, J = 7.3 Hz, 1H, CH), 3.73 (s, 3H, OCH3), 2.82 (s, 3H, CH3), 2.24 (s, 3H, CH3), 2.15 (s, 3H, CH3), 1.09 (d, J = 7.3 Hz, 3H, CH3); 13C NMR (100 MHz, DMSO-d6) δ 171.4 (C=O ester), 163.0 (C=O), 160.4 (C Het), 139.1 (C Het), 139.0 (C Ar), 138.6 (C Ar), 136.0 (C Ar), 130.4 (CH Ar), 129.7 (CH Ar), 129.5 (CH Ar), 56.0 (CH), 52.1 (OCH3), 18.0 (CH3), 17.8 (CH3), 14.7 (CH3), 14.1 (CH3); EI-MS m/z (%): 333 [M]+ (1), 302 [M–OCH3]+ (5), 290 (9), 272 [M–CO2CH3]+ (10), 246 [M–CH(CH3)CO2CH3]+ (28), 206 [M–HetCO]+ (92), 99 [HetCO–N2]+· (100). Analysis calculated for C16H19N3O3S (Mr = 333.41): C 57.64, H 5.74, N 12.60, S 9.62; found C 57.39, H 5.54, N 12.39, S 9.48%.
Methyl-N-(4-methyl-1,2,3-thiadiazole-5-carbonyl)-N-(2,4,6-trimethylphenyl)-(RS)-alaninate (1e): light yellow powder, yield 0.285 g (82%); m.p. 120–121 °C; IR, ν, cm−1: 2989, 2918, 2849, 1753 (C=O), 1634 (C=O), 1474, 1455, 1375, 1350, 1306, 1263, 1209, 1166, 1141, 1112, 1084, 1033, 1010, 981; 1H NMR (400 MHz, DMSO-d6) δ 7.07 (s, 1H, H Ar), 7.05 (s, 1H, H Ar), 4.63 (q, J = 7.2, 1H, CH), 3.72 (s, 3H, OCH3), 2.82 (s, 3H, CH3), 2.31 (s, 3H, CH3), 2.19 (s, 3H, CH3), 2.09 (s, 3H, CH3), 1.08 (d, J = 7.3, 3H, CH3); 13C NMR (100 MHz, DMSO-d6) δ 171.5 (C=O), 163.0 (C=O), 160.5 (C Het), 140.1 (C Het), 139.0 (C Ar), 138.6 (C Ar), 138.2 (C Ar), 133.4 (C Ar), 130.3 (CH Ar), 130.1 (CH Ar), 56.1 (CH), 52.0 (OCH3), 20.6 (CH3 Ar), 17.9 (CH3 Ar), 17.7 (CH3 Ar), 14.7 (CH3), 14.2 (CH3); EI-MS m/z (%): 347 [M]+ (2), 319 [M–N2]+ (8), 304 (11), 286 [M–CO2CH3]+ (14), 272 (7), 260 [M–CH(CH3)CO2CH3]+ (32), 244 (23), 232 (21), 220 [M–HetCO]+· (99), 146, 119, 99 [HetCO–N2]+ (100). Analysis calculated for C17H21N3O3S (Mr = 347.43): C 58.77, H 6.09, N 12.09, S 9.23; found C 58.65, H 6.12, N 11.83, S 9.01%.
Methyl-N-(4-methyl-1,2,3-thiadiazole-5-carbonyl)-N-(3-chlorophenyl)-(RS)-alaninate (1f): white powder, yield 0.330 g (97%); m.p. 107–109 °C; IR, ν, cm−1: 2957, 1740 (C=O), 1636 (C=O), 1584, 1472, 1418, 1384, 1347, 1261, 1203, 1121, 1017, 976; 1H NMR (400 MHz, DMSO-d6) δ 7.54 (br. s, 1H, CH Ar), 7.47 (d, J = 7.8 Hz, 1H, CH Ar), 7.41 (dd, J = 7.8, 7.6 Hz, 1H, CH Ar), 7.36 (d, J = 7.6 Hz, 1H, CH Ar), 5.02 (q, J = 7.1 Hz, 1H, CH), 3.75 (s, 3H, OCH3), 2.65 (s, 3H, CH3), 1.35 (d, J = 7.1 Hz, 3H, CH3); 13C NMR (100 MHz, DMSO-d6) δ 171.1 (C=O ester), 160.4 (C=O), 159.0 (C Het), 142.2 (C Het), 140.2 (C Ar), 133.5 (C Ar), 131.1 (CH Ar), 129.4 (CH Ar), 129.3 (CH Ar), 128.2 (CH Ar), 56.5 (CH), 52.4 (OCH3), 14.7 (CH3), 12.9 (CH3); EI-MS m/z (%): 341 [M+2]+ (1), 339 [M]+ (1), 308 [M–OCH3]+ (2), 279 [M–HCO2CH3]+ (8), 254 (8), 252 (21), 214 [M+2–HetCO]+ (9), 212 [M–HetCO]+ (27), 192 (2), 168 (7), 152 (5), 138 (14), 113 (8), 111 (24), 99 [HetCO–N2]+ (100). Analysis calculated for C14H14ClN3O3S (Mr = 339.79): C 49.49, H 4.15, N 12.37, S 9.44; found C 49.58, H 4.28, N 12.09, S 9.12%.
Methyl-N-(4-methyl-1,2,3-thiadiazole-5-carbonyl)-N-(4-chlorophenyl)-(RS)-alaninate (1g): light yellow oil, yield 0.296 g (87%); IR, ν, cm−1: 2994, 2951, 1742 (C=O), 1644 (C=O), 1483, 1454, 1383, 1332, 1284, 1208, 1151, 1115, 1085, 1047, 1014, 978; 1H NMR (400 MHz, DMSO-d6) δ 7.46 (d, J = 8.6 Hz, 2H, H Ar), 7.41 (d, J = 8.6 Hz, 2H, H Ar), 5.03 (q, J = 7.2 Hz, 1H, CH), 3.75 (s, 3H, OCH3), 2.65 (s, 3H, HetCH3), 1.32 (d, J = 7.2 Hz, 3H, CH3); 13C NMR (100 MHz, DMSO-d6) δ 171.2 (C=O), 160.5 (C=O), 159.0 (C Het), 142.3 (C Het), 137.7 (C Ar), 133.9 (C Ar), 131.3 (CH Ar), 129.6 (CH Ar), 56.3 (CH), 52.4 (OCH3), 14.8 (CH3), 12.9 (CH3 Het); EI-MS m/z (%): 341 [M+2]+ (1), 339 [M]+ (2), 308 [M–OCH3]+ (2), 279 [M–HCO2CH3]+ (6), 212 [M–HetCO]+ (34), 252 [M–CH(CH3)CO2CH3]+ (33), 99 [HetCO–N2]+ (100). Analysis calculated for C14H14ClN3O3S (Mr = 339.79): C 49.49, H 4.15, N 12.37, S 9.44; found C 49.35, H 4.48, N 12.11, S 9.30%.
Methyl-N-(4-methyl-1,2,3-thiadiazole-5-carbonyl)-N-(3,5-dichlorophenyl)-(RS)-alaninate (1h): colorless oil, yield 0.322 g (86%); IR, ν, cm−1: 3084, 2950, 2950, 1741 (C=O), 1651 (C=O), 1566, 1494, 1458, 1434, 1401, 1380, 1346, 1285, 1211, 1134, 1106, 1089, 1054, 1013, 976; 1H NMR (400 MHz, DMSO-d6) δ 7.67 (br.s., 1H, CH Ar), 7.54 (br.s., 2H, CH Ar), 5.00 (q, J = 7.2, 1H, CH), 3.75 (s, 3H, OCH3), 2.63 (s, 3H, CH3), 1.38 (d, J = 7.2 Hz, 3H, CH3); 13C NMR (100 MHz, DMSO-d6) δ 171.1 (C=O), 160.4 (C=O), 158.8 (C Het), 142.1 (C Het), 141.3, 134.5 (CH Ar), 129.1, 128.3 (CH Ar), 56.9 (CH), 52.5 (OCH3), 14.7 (CH3), 12.8 (CH3); EI-MS m/z (%): 376 [M+2]+ (1), 374 [M]+ (1), 342 [M–CH3OH]+ (2), 313 [M+1–HCO2CH3]+ (4), 288 [M+2–CH(CH3)CO2CH3]+ (14), 286 [M–CH(CH3)CO2CH3]+ (14), 274 (4), 252 (7), 250 [M+4–HetCO]+ (9), 248 [M+2–HetCO]+ (14), 246 [M–HetCO]+ (24), 224 (2), 202 (6), 188 (4), 172 (6), 167 (5), 152 (4), 147 (9), 145 (14), 124 (3), 109 (7), 101 (5), 100 (6), 99 [HetCO–N2]+ (100). Analysis calculated for C14H13Cl2N3O3S (Mr = 374.24): C 44.93, H 3.50, N 11.23, S 8.57; found C 44.75, H 3.58, N 11.02, S 8.36%.
Methyl-N-(4-methyl-1,2,3-thiadiazole-5-carbonyl)-N-(3-methyl-4-chlorophenyl)-(RS)-alaninate (1i) (isomers ration = 3:1): white powder, yield 0.265 g (75%); m.p. 98–100 °C; IR, ν, cm−1: 2985, 1739 (C=O), 1650 (C=O), 1572, 1490, 1448, 1353, 1266, 1209, 1195, 1113, 1013, 967; 1H NMR (400 MHz, DMSO-d6) δ 7.60–7.55 (m, 1H, CH Ar minor+major), 7.48–7.77 (m, 1H, CH Ar min+maj), 7.35–7.31 (m, 1H, CH Ar min+maj), 4.87 (q, J = 7.3 Hz, 1H, CH maj), 4.65 (q, J = 7.0 Hz, 1H, CH min), 3.75 (s, 3H, OCH3 maj), 3.73 (s, 3H, OCH3 min), 2.76 (3H, s, CH3 maj), 2.25 (3H, s, CH3), 1.47 (d, J = 7.1 Hz, 3H, CH3 min), 1.25 (d, J = 7.3 Hz, 3H, CH3 maj); 13C NMR (100 MHz, DMSO-d6) δ 171.1 (C=O maj), 170.88 (C=O min), 161.3 (C=O min), 161.2 (C=O maj), 160.2 (C Het min), 160.1 (C Het maj), 140.7 (C Het maj), 140.6 (C Het min), 138.9 (C Ar maj+min), 136.1 (C Ar maj), 135.6 (C Ar min), 135.2 (C Ar maj), 134.9 (C Ar min), 130.9 (CH Ar maj), 130.6 (CH Ar min), 129.5 (CH Ar maj), 129.1 (CH Ar min), 128.4 (CH Ar min), 128.3 (CH Ar maj), 58.8 (CH min), 56.5 (CH maj), 52.4 (OCH3 min), 52.3 (OCH3 maj), 15.5(CH3 maj), 15.3 (CH3 min), 15.0 (CH3 min), 14.0 (CH3 maj), 13.5 (CH3 Het maj), 13.4 (CH3 Het min); EI-MS m/z (%): 355 [M+2]+ (1), 353 [M]+ (1), 322 [M–OCH3]+ (3), 310 (1), 295 [M+2–HCO2CH3]+ (3), 290 (8), 266 [M–CH(CH3)CO2CH3]+ (14), 254 (9), 238 (16), 230 (12), 226 [M–HetCO]+ (40), 196 (2), 182 (5), 168 (4), 154 (4), 152 (9), 132 (9), 117 (16), 99 [HetCO–N2]+ (100). Analysis calculated for C15H16ClN3O3S (Mr = 353.82): C 50.92, H 4.56, N 11.88, S 9.06; found C 50.69, H 4.63, N 11.73, S 8.86%.
Methyl-N-(4-methyl-1,2,3-thiadiazole-5-carbonyl)-N-(3-methoxylphenyl)-(RS)-alaninate (1j): dark yellow oil, yield 0.268 g (80%); IR, ν, cm−1: 2996, 2950, 2839, 1742 (C=O), 1645 (C=O), 1599, 1488, 1452, 1382, 1328, 1286, 1206, 1167, 1108, 1088, 1038, 975; 1H NMR (400 MHz, DMSO-d6) δ 7.30 (dd, J = 8.4, 8.0 Hz, 1H, CH Ar), 6.98–6.93 (m, 3H, CH Ar), 5.01 (q, J = 7.2, 1H, CH), 3.74 (s, 3H, OCH3), 3.72 (s, 3H, OCH3), 2.67 (s, 3H, CH3), 1.34 (d, J = 7.2 Hz, 3H, CH3); 13C NMR (100 MHz, DMSO-d6) δ 171.2 (C=O), 160.4 (C=O), 159.8, 159.4, 142.2, 139.8, 130.4 (CH Ar), 121.4, 115.3, 115.0, 56.4 (CH), 55.4 (OCH3), 52.3 (OCH3), 14.7 (CH3), 13.1 (CH3); EI-MS m/z (%): 335 [M]+ (1), 307 [M–N2]+ (26), 273 (13), 248 [M–CH(CH3)CO2CH3]+ (31), 214 (21), 208 [M–HetCO]+ (27), 149 (14), 134 (28), 122 (12), 107 (21), 99 [HetCO–N2]+ (100). Analysis calculated for C15H17N3O4S (Mr = 335.38): C 53.72, H 5.11, N 12.53, S 9.56; found C 53.79, H 4.96, N 12.38, S 9.34%.
Methyl-N-(4-methyl-1,2,3-thiadiazole-5-carbonyl)-N-(4-methoxylphenyl)-(RS)-alaninate (1k): yellow oil, yield 0.288 g (86%); IR, ν, cm−1: 2996, 2952, 2841, 1743 (C=O), 1657 (C=O), 1606, 1579, 1512, 1458, 1385, 1335, 1298, 1247, 1182, 1152, 1114, 1089, 1029, 979; 1H NMR (400 MHz, DMSO-d6) δ 7.29 (d, J = 8.8 Hz, 2H, CH Ar), 6.94 (d, J = 8.8 Hz, 2H, CH Ar), 5.02 (q, J = 7.2 Hz, 1H, CH), 3.75 (s, 3H, OCH3), 3.73 (s, 3H, OCH3), 2.70 (s, 3H, CH3), 1.29 (d, J = 7.2 Hz, 3H, CH3); 13C NMR (100 MHz, DMSO-d6) δ 171.4 (C=O), 160.7 (C=O), 159.9 (C Het), 159.7 (C Ar), 142.0 (C Het), 131.0 (CH Ar), 130.9 (C Ar), 114.8 (CH Ar), 56.1 (CH), 55.4 (OCH3), 52.3 (OCH3), 14.9 (CH3), 13.3 (CH3); EI-MS m/z (%): 337 [M+2]+ (4), 336 [M+1]+ (14), 335 [M]+ (49), 304 [M–OCH3]+ (6), 292 (5), 275 [M–HCO2CH3]+ (9), 264 (4), 248 [M–CH(CH3)CO2CH3]+ (99), 236 (8), 220 (16), 208 [M–HetCO]+ (96), 186 (10), 176 (8), 162 (17), 149 (49), 134 [M–Het]+ (99), 122 (24), 99 [HetCO–N2]+ (100). Analysis calculated for C15H17N3O4S (Mr = 335.38): C 53.72, H 5.11, N 12.53, S 9.56; found C 53.66, H 5.24, N 12.58, S 9.31%.
Methyl-N-(4-methyl-1,2,3-thiadiazole-5-carbonyl)-N-(3-trifluoromethylphenyl)-(RS)-alaninate (1l): white crystals, yield 0.358 g (96%); m.p. 71–72 °C; IR, ν, cm−1: 2960, 1741 (C=O), 1646 (C=O), 1587, 1487, 1435, 1391, 1353, 1327, 1301, 1255, 1212, 1168, 1140, 1117, 1092, 1069, 1050, 1001, 978; 1H NMR (400 MHz, DMSO-d6) δ 7.80 (br.s., 1H, CH Ar), 7.69–7.55 (m, 2H, CH Ar), 7.62 (dd, J = 7.8, 7.6 Hz, 1H, CH Ar), 5.08 (q, J = 7.1 Hz, 1H, CH), 3.76 (s, 3H, OCH3), 2.61 (s, 3H, CH3), 1.35 (d, J = 7.1 Hz, 3H, CH3); 13C NMR (100 MHz, DMSO-d6) δ 171.3 (C=O), 160.6 (C=O), 158.5 (C Het), 142.4 (C Het), 139.7 (C Ar), 133.4 (CH Ar), 130.9 (CH Ar), 130.0 (q, JC-F = 32.4 Hz, C Ar), 123.4 (q, JC-F = 272.4 Hz, CF3), 126.3 (d, JC-F = 3.4 Hz, CH Ar), 125.9 (d, JC-F = 2.8 Hz, CH Ar), 56.5 (CH), 52.5 (OCH3), 14.8 (CH3), 12.7 (CH3); EI-MS m/z (%): 374 [M+1]+ (1), 342 [M–CH3OH]+ (1), 313 [M–HCO2CH3]+ (4), 302 (1), 286 [M–CH(CH3)CO2CH3]+ (30), 274 (4), 252 (4), 246 [M–HetCO]+ (25), 224 (2), 216 (1), 202 (11), 186 (5), 172 (7), 159 (1), 145 (19), 125 (3), 99 [HetCO–N2]+ (100). Analysis calculated for C15H14F3N3O3S (Mr = 373.35): C 48.26, H 3.78, N 11.26, S 8.59; found C 48.15, H 3.60, N 10.98, S 8.43%.
Methyl-N-(3,4-dichloroisothiazole-5-carbonyl)-N-phenyl)-(RS)-alaninate (2a): light yellow oil, yield 0.255 g (71%); IR, ν, cm−1: 3063, 2994, 2952, 1745 (C=O), 1652 (C=O), 1594, 1493, 1454, 1397, 1294, 1208, 1113, 1085, 1026, 951; 1H NMR (400 MHz, DMSO-d6) δ 7.38–7.43 (m, 5H, CH Ar), 5.01 (q, J = 7.2, 1H, CH), 3.74 (s, 3H, OCH3), 1.31 (d, J = 7.2, 3H, CH3); 13C NMR (100 MHz, DMSO-d6) δ 170.9 (C=O), 158.7 (C=O), 155.5 (C Het), 146.2 (C Het), 138.1 (C Ar), 129.4 (CH Ar), 129.4 (CH Ar), 129.3 (CH Ar), 120.5 (C Het), 56.2 (CH), 52.3 (OCH3), 14.7 (CH3); EI-MS m/z (%): 362 [M+4]+ (3), 360 [M+2]+ (12), 358 [M]+ (17), 329 [M+2–OCH3]+ (1), 327 [M–OCH3]+ (2), 303 [M+4–CO2CH3]+ (13), 301 [M+2–CO2CH3]+ (68), 299 [M–CO2CH3]+ (95), 184 (14), 183 [HetCO+2]+ (5), 182 (70), 181 (9), 180 [HetCO]+ (100), 118 (16), 104 (33), 77 (62). Analysis calculated for C14H12Cl2N2O3S (Mr = 359.22): C 46.81, H 3.37, N 7.80, S 8.92; found C 46.59, H 3.52, N 7.73, S 8.90%.
Methyl-N-(3,4-dichloroisothiazole-5-carbonyl)-N-(3-methylphenyl)-(RS)-alaninate (2b): colorless oil, yield 0.336 g (90%). IR, ν, cm−1: 2992, 2951, 1743 (C=O), 1650 (C=O), 1603, 1586, 1488, 1455, 1385, 1293, 1212, 1192, 1140, 1110, 1085, 1050, 1050, 1002, 977; 1H NMR (400 MHz, DMSO-d6) δ 7.29–7.19 (4H, m, H Ar), 4.97 (q, J = 7.2 Hz, 1H, CH), 3.73 (s, 3H, OCH3), 2.27 (s, 3H, CH3), 1.33 (d, J = 7.2 Hz, 3H, CH3). 13C NMR (100 MHz, DMSO-d6) δ 170.9 (C=O), 158.6 (C=O), 155.3 (C Het), 146.3 (C Het), 139.1 (CH Ar), 138.1 (C Ar), 130.1, 129.7, 129.2, 126.3 (CH Ar), 120.9 (C Het), 56.4 (CH), 52.3 (OCH3), 20.7 (CH3), 14.7 (CH3); EI-MS m/z (%): 376 [M+4]+ (3), 374 [M+2]+ (15), 372 [M]+ (20), 341 [M–OCH3]+ (2), 317 [M+4–CO2CH3]+ (15), 315 [M+2–CO2CH3]+ (74), 313 [M–CO2CH3]+ (100), 305 (1), 277 (2), 265 (1), 251 (1), 237 (1), 184 [HetCO+4]+ (12), 182 [HetCO+2]+ (62), 180 [HetCO]+ (89), 164 (1), 148 (1), 133 (13), 132 (19), 118 (31), 104 (3); Analysis calculated for C15H14Cl2N2O3S (Mr = 373.25): C 48.27, H 3.78, N 7.51, S 8.59; found C 48.49, H 3.91, N 7.78, S 8.48%.
Methyl-N-(3,4-dichloroisothiazole-5-carbonyl)-N-(p-tolyl)-(RS)-alaninate (2c): light yellow oil, yield 0.280 g (75%). IR, ν, cm−1: 2993, 2951, 1744 (C=O), 1650 (C=O), 1510, 1391, 1293, 1206, 1110, 1084, 1045, 1022, 951; 1H NMR (400 MHz, DMSO-d6) δ 7.31 (d, J =8.1 Hz, 2H, CH Ar), 7.19 (d, J =8.1 Hz, 2H, CH Ar), 5.01 (1H, q, J = 7.1, CH), 3.73 (3H, s, OCH3), 2.28 (3H, s, CH3), 1.30 (3H, d, J = 7.2, CH3); 13C NMR (100 MHz, DMSO-d6) δ 171.0 (C=O), 158.7 (C=O), 155.5 (C Het), 146.3 (C Het), 139.2 (C Ar), 135.4 (C Ar), 129.9 (CH Ar), 129.2 (CH Ar), 120.7 (C Het), 56.1 (CH), 52.3 (OCH3), 20.6 (Ar CH3), 14.7 (CH3); EI-MS m/z (%): 376 [M+4]+ (4), 374 [M+2]+ (18), 372 [M]+ (27), 343 [M+2–OCH3]+ (1), 341 [M–OCH3]+ (2), 317 [M+4–CO2CH3]+ (15), 315 [M+2–CO2CH3]+ (70), 313 [M–CO2CH3]+ (97), 184 [HetCO+4]+ (13), 183 [HetCHO+2]+ (4), 182 [HetCO+2]+ (67), 181 [HetCHO]+ (8), 180 [HetCO]+ (100), 118 (35), 91 (55). Analysis calculated for C15H14Cl2N2O3S (Mr = 373.25): C 48.27, H 3.78, N 7.51, S 8.59; found C 48.38, H 3.61, N 7.44, S 8.78%.
Methyl-N-(3,4-dichloroisothiazole-5-carbonyl)-N-(2,6-dimethylphenyl)-(RS)-alaninate (2d): white powder, yield 0.279 g (72%); m.p. 120–121 °C; IR, ν, cm−1: 2987, 2957, 1749 (C=O), 1645 (C=O), 1453, 1385, 1336, 1308, 1267, 1207, 1180, 1121, 1085, 979; 1H NMR (400 MHz, DMSO-d6) δ 7.37 (t, J = 7.6 Hz, 1H, H Ar), 7.25 (dd, J = 7.2, 6.8 Hz, 2H, H Ar), 4.66 (q, J = 7.3 Hz, 1H, CH), 3.73 (s, 3H, OCH3), 2.31 (s, 3H, CH3), 2.21 (s, 3H, CH3), 1.10 (d, J = 7.3 Hz, 3H, CH3); 13C NMR (100 MHz, DMSO-d6) δ 171.2 (C=O), 158.1 (C=O), 151.1 (C Het), 147.8 (C Het), 139.3 (C Ar), 138.9 (C Ar), 135.0 (C Ar), 130.6 (CH Ar), 129.7 (CH Ar), 129.5 (CH Ar), 125.0 (C Het), 56.2 (CH), 52.1 (OCH3), 18.2 (CH3), 17.9 (CH3), 14.5 (CH3); EI-MS m/z (%): 390 [M+4]+ (3), 389 [M+3]+ (3), 388 [M+2]+ (15), 387 [M+1]+ (5), 386 [M]+ (23), 354 (4), 331 [M+4–CO2CH3]+ (14), 330 [M+4–HCO2CH3]+ (12), 329 [M+4–CO2CH3]+ (68), 328 [M+2–HCO2CH3]+ (19), 327 [M–CO2CH3]+ (100), 326 [M–HCO2CH3]+ (1), 267 (12), 265 (18), 239 (19), 237 (28), 206 [M–HetCO]+ (5), 184 [HetCO+4]+ (13), 182 [HetCO+2]+ (68), 180 [HetCO]+ (97), 147 (13), 146 (37), 132 (69), 131 (15), 117 (31), 105 (38). Analysis calculated for C16H16Cl2N2O3S (Mr = 387.28): C 49.62, H 4.16, N 7.23, S 8.28; found C 49.45, H 4.39, N 7.17, S 8.35%.
Methyl-N-(3,4-dichloroisothiazole-5-carbonyl)-N-(2,4,6-trimethylphenyl)-(RS)-alaninate (2e): white powder, yield 0.309 g (77%); m.p. 120–121 °C; IR, ν, cm−1: 2989, 2947, 1746 (C=O), 1644 (C=O), 1481, 1452, 1434, 1377, 1338, 1303, 1303, 1259, 119, 1167, 1110, 1082, 1035, 980; 1H NMR (400 MHz, DMSO-d6) δ 7.07 (d, J = 5.4 Hz, 2H, CH Ar), 4.62 (q, J = 7.3 Hz, 1H, CH), 3.72 (s, 3H, OCH3), 2.30 (s, 3H, CH3), 2.26 (s, 3H, CH3), 2.15 (s, 3H, CH3), 1.08 (d, J = 7.3 Hz, 3H, CH3); 13C NMR (100 MHz, DMSO-d6) δ 171.3 (C=O), 158.2 (C=O), 151.0 (C Het), 147.8 (C Het), 140.4 (C Ar), 138.9 (C Ar), 138.6 (C Ar), 132.4 (C Ar), 130.3 (CH Ar), 130.1 (CH Ar), 125.0 (C Het), 56.3 (CH), 52.1 (OCH3), 20.6 (CH3 Ar), 18.1 (CH3 Ar), 17.8 (CH3 Ar), 14.5 (CH3); EI-MS m/z (%): 404 [M+4]+ (9), 403 [M+3]+ (8), 402 [M+2]+ (39), 401 [M+1]+ (13), 400 [M]+ (54), 370 [M+2–CH3OH]+ (4), 369 [M–OCH3]+ (5), 368 [M–CH3OH]+ (5), 345 [M+4–CO2CH3]+ (14), 344 (14), 343 [M+2–CO2CH3]+ (67), 342 (20), 341 [M–CO2CH3]+ (100), 267 (43), 265 (62), 239 (42), 237 (60), 220 [M–HetCO]+ (6), 184 [HetCO+4]+ (9), 182 [HetCO+2]+ (44), 180 [HetCO]+ (64), 161 (40), 160 (37), 146 (79), 131 (37), 104 (7), 103 (8). Analysis calculated for C17H18Cl2N2O3S (Mr = 401.30): C 50.88, H 4.52, N 6.98, S 7.99; found C 50.96, H 4.75, N 7.06, S 8.09%.
Methyl-N-(3,4-dichloroisothiazole-5-carbonyl)-N-(3-chlorophenyl)-(RS)-alaninate (2f): colorless oil, yield 0.382 g (97%). IR, ν, cm−1: 2993, 2951, 1743 (C=O), 1653 (C=O), 1587, 1509, 1475, 1456, 1434, 1394, 1291, 1249, 1207, 1119, 1081, 1048, 1001, 975; 1H NMR (400 MHz, DMSO-d6) δ 7.60 (s, 1H, CH Ar), 7.46–7.39 (m, 3H, CH Ar), 5.02 (q, J = 7.2 Hz, 1H, CH), 3.74 (s, 3H, OCH3), 1.34 (d, J = 7.2 Hz, CH3); 13C NMR (100 MHz, DMSO-d6) δ 170.9 (C=O), 158.8 (C=O), 155.6 (C Het), 146.2 (C Het), 139.6, 133.2, 130.9, 129.4, 129.3, 128.0, 120.2 (C Het), 56.3 (CH), 52.4 (OCH3), 14.7 (CH3); EI-MS m/z (%): 396 [M+4]+ (5), 394 [M+2]+ (13), 392 [M]+ (13), 363 [M+2–OCH3]+ (2), 337 [M+4–CO2CH3]+ (24), 335 [M+2–CO2CH3]+ (66), 333 [M–CO2CH3]+ (64), 212 [M–HetCO]+ (6), 184 [HetCO+4]+ (14), 182 [HetCO+2]+ (69), 180 [HetCO]+ (100), 154 (3), 152 (7), 138 (14), 113 (7), 111 (21). Analysis calculated for C14H11Cl3N2O3S (Mr = 393.66): C 42.72, H 2.82, N 7.12, S 8.14; found C 42.63, H 2.68, N 7.31, S 8.28%.
Methyl-N-(3,4-dichloroisothiazole-5-carbonyl)-N-(p-chlorophenyl)-(RS)-alaninate (2g): light yellow oil, yield 0.358 g (91%). IR, ν, cm−1: 2993, 2952, 1723 (C=O), 1651 (C=O), 1489, 1455, 1394, 1290, 1207, 1113, 1085, 1046, 1016, 952; 1H NMR (400 MHz, DMSO-d6) δ 7.47 (s, 4H, H Ar), 5.01 (q, J = 7.2 Hz, 1H, CH), 3.73 (s, 3H, OCH3), 1.31 (d, J = 7.2 Hz, 3H, CH3); 13C NMR (100 MHz, DMSO-d6) δ 170.9 (C=O), 158.8 (C=O), 155.6 (C Het), 146.2 (C Het), 137.0 (C Ar), 133.9 (C Ar), 131.1 (CH Ar), 129.4 (CH Ar), 120.3 (C Het), 56.1 (CH), 52.3 (OCH3), 14.7 (CH3); EI-MS m/z (%): 396 [M+4]+ (5), 394 [M+2]+ (14), 392 [M]+ (13), 363 [M+2–OCH3]+ (1), 361 [M–OCH3]+ (1), 337 [M+4–CO2CH3]+ (19), 335 [M+2–CO2CH3]+ (54), 333 [M–CO2CH3]+ (54), 183 [HetCHO+2]+ (4), 182 [HetCO+2]+ (68), 181 [HetCHO]+ (8), 180 [HetCO]+ (100), 118 (2), 111 (24). Analysis calculated for C14H11Cl3N2O3S (Mr = 393.66): C 42.72, H 2.82, N 7.12, S 8.14; found C 42.55, H 2.94, N 7.22, S 7.95%.
Methyl-N-(3,4-dichloroisothiazole-5-carbonyl)-N-(3,5-dichlorophenyl)-(RS)-alaninate (2h): colorless oil, yield 0.253 g (59%). IR, ν, cm−1: 3077, 2993, 2952, 1743 (C=O), 1658 (C=O), 1580, 1567, 1508, 1435, 1393, 1288, 1209, 1131, 1104, 1084, 1054, 998; 1H NMR (400 MHz, DMSO-d6) δ 7.66 (br. s., 1H, CH Ar), 7.59 (br.s., 2H, H Ar), 5.00 (q, J = 7.1 Hz, 1H, CH), 3.74 (s, 3H, OCH3), 1.36 (d, J = 7.1 Hz, 3H, CH3); 13C NMR (100 MHz, DMSO-d6) δ 170.8 (C=O), 158.8 (C=O), 155.5 (C Het), 146.2 (C Het), 140.5 (C Ar), 134.1 (CH Ar), 129.1 (C Ar), 128.2 (C Ar), 120.0 (C Het), 56.6 (CH), 52.4 (OCH3), 14.6 (CH3); EI-MS m/z (%): 432 [M+4]+ (1), 431 [M+3]+ (1), 430 [M+2]+ (6), 429 [M+1]+ (2), 428 [M]+ (11), 426 (8), 397 (2), 246 (4), 184 [HetCO+4]+ (14), 183 [HetCHO+2]+ (5), 182 [HetCO+2]+ (69), 180 [HetCO]+ (100), 145 (12), 117 (4), 109 (6); Analysis calculated for C14H10Cl4N2O3S (Mr = 428.11): C 39.28, H 2.35, N 6.54, S 7.49; found C 39.39, H 2.58, N 6.46, S 7.33%.
Methyl-N-(2-methyl-3-chloroisothiazole-5-carbonyl)-N-(3,5-dichlorophenyl)-(RS)-alaninate (2i) (isomers ration 4:1): colorless oil, yield 0.273 g (67%). IR, ν, cm−1: 2980, 2960, 1736 (C=O), 16,501 (C=O), 1588, 1568, 1497, 1431, 1382, 1342, 1312, 1267, 1214, 1198, 1177, 1115, 1088, 1050, 1014, 978; 1H NMR (400 MHz, DMSO-d6) δ 7.58–7.49 (m, 2H, CH Ar min+maj), 7.34–7.30 (m, 1H, CH Ar min+maj), 4.84–4.79 (m, 1H, CH maj), 4.71–4.64 (m, 1H, CH min), 3.75 (s, 3H, OCH3 maj), 3.73 (s, 4H, OCH3 min), 2.33 (s, 3H, CH3 min+maj), 1.48 (d, J = 6.5 Hz, 3H, CH3 min), 1.28 (d, J = 6.8 Hz, 3H, CH3 maj); 13C NMR (100 MHz, DMSO-d6) δ 170.8 (C=O maj), 170.6 (C=O min), 158.4 (C=O min), 158.2 (C=O maj), 153.5 (C Het min), 153.4 (C Het maj), 147.2 (C Het min), 147.2 (C Het maj), 140.1 (min), 138.2 (maj), 136.1 (maj), 135.7 (min), 135.1 (maj), 134.9 (min), 130.9 (maj), 130.6 (min), 129.5 (maj), 129.2 (min), 128.1 (min), 128.0 (maj), 122.7 (C Het min), 122.6 (C Het maj), 58.9 (CH min), 56.8 (CH maj), 52.4 (OCH3 maj), 52.3 (OCH3 min), 15.8 (min), 15.5 (maj), 14.9 (min), 13.8 (maj); EI-MS m/z (%): 410 [M+4]+ (2), 408 [M+2]+ (7). 406 [M]+ (6), 374 [M–CH3OH]+ (2), 351 [M–CH3OH]+ (20), 349 [M+2–CO2CH3]+ (54), 347 [M–CO2CH3]+ (55), 226 [M–HetCO]+ (7), 184 [HetCO+4]+ (13), 182 [HetCO+2]+ (67), 180 [HetCO]+ (100), 166 (6), 152 (11), 131 (6), 117 (24), 99 (5), 89 (18); Analysis calculated for C15H13Cl3N2O3S (Mr = 407.69): C 44.19, H 3.21, N 6.87, S 7.86; found C 44.27, H 3.45, N 6.62, S 7.94%.
Methyl-N-(3,4-dichloroisothiazole-5-carbonyl)-N-(3-methoxyphenyl)-(RS)-alaninate (2j): colorless oil, yield 0.327 g (84%). IR, ν, cm−1: 2998, 2950, 2839, 1743 (C=O), 1653 (C=O), 1599, 1587, 1488, 1453, 1434, 1395, 1293, 1204, 1176, 1109, 1085, 1038, 996; 1H NMR (400 MHz, DMSO-d6) δ 7.29 (dd, J = 8.1, 8.1 Hz, 1H, CH Ar), 7.05 (s, 1H, CH Ar), 7.00 (d, J = 7.8, Hz, CH Ar), 6.95 (dd, J = 8.3, 2.1 Hz, 1H, CH Ar), 5.01 (q, J = 7.2 Hz, 1H, CH), 3.74 (s, 3H, OCH3), 3.72 (s, 3H, OCH3), 1.34 (d, J = 7.2 Hz, 3H, CH3); 13C NMR (100 MHz, DMSO-d6) δ 170.9 (C=O), 159.6 (C Ar), 158.7 (C=O), 155.5 (C Het), 146.2 (C Het), 139.2 (C Ar), 130.2 (CH Ar), 121.3 (CH Ar), 120.7 (C Het), 115.2 (CH Ar), 115.1 (CH Ar), 56.2 (CH), 55.3 (ArOCH3), 52.3 (OCH3), 14.7 (CH3); MS (EI, 70 eV), m/z (Irel,%): 392 (2), 391 (2), 390 (10), 389 (3), 388 (14), 353 (17), 331 (69), 330 (17), 329 (98), 295 (3), 293 (8), 208 (9), 184 (13), 182 (69), 180 (100), 148 (13), 134 (23), 107 (22); EI-MS m/z (%): 392 [M+4]+ (2), 391 [M+3]+ (1), 390 [M+2]+ (10), 389 [M+1]+ (3), 388 [M]+ (14), 353 (17), 329 [M–CO2CH3]+ (98), 321 (22), 293 (8), 208 [M–HetCO]+ (9), 184 [HetCO+4]+ (13), 183 (4), 182 [HetCO+2]+ (69), 181 (7), 180 [HetCO]+ (100), 148 (13), 134 (23), 117 (4), 107 (22). Analysis calculated for C15H14Cl2N2O4S (Mr = 389.25): C 46.29, H 3.63, N 7.20, S 8.24; found C 46.03, H 3.48, N 7.09, S 7.97%.
Methyl-N-(3,4-dichloroisothiazole-5-carbonyl)-N-(p-methoxyphenyl)-(RS)-alaninate (2k): colorless oil, yield 0.319 g (82%). IR, ν, cm−1: 2922, 2952, 2840, 1743 (C=O), 1649 (C=O), 1606, 1580, 1508, 1456, 1388, 1292, 1247, 1206, 1180, 1170, 1108, 1085, 1027, 981; 1H NMR (400 MHz, DMSO-d6) δ 7.36 (d, J = 8.7 Hz, 2H, CH Ar), 6.94 (d, J = 8.7 Hz, 2H, CH Ar), 5.02 (q, J = 7.2 Hz, 1H, CH), 3.74 (s, 3H, OCH3), 3.73 (s, 3H, OCH3), 1.29 (d, J = 7.2 Hz, 3H, CH3); 13C NMR (100 MHz, DMSO-d6) δ 171.0 (C=O), 159.7 (C=O), 158.9 (C Ar), 155.2 (C Het), 146.4 (C Het), 130.9 (CH Ar), 130.2 (C Ar), 120.9 (C Het), 114.5 (CH Ar), 55.9, 55.4, 52.2, 14.7 (CH3); EI-MS m/z (%): 392 [M+4]+ (8), 391 [M+3]+ (7), 390 [M+2]+ (37), 389 [M+1]+ (11), 388 [M]+ (53), 357 [M–OCH3]+ (3), 356 [M–CH3OH]+ (3), 331 [M+2–CO2CH3]+ (72), 330 [M+2–HCO2CH3]+ (18), 329 [M–CO2CH3]+ (100), 265 (9), 237 (9), 208 [M–HetCO]+ (18), 184 [HetCO+4]+ (10), 180 [HetC·O]+ (79), 149 (49), 134 (73), 122 (11), 107 (11); Analysis calculated for C15H14Cl2N2O4S (Mr = 389.25): C 46.29, H 3.63, N 7.20, S 8.24; found C 46.14, H 3.55, N 7.04, S 8.01%.
Methyl-N-(3,4-dichloroisothiazole-5-carbonyl)-N-(3-trifluoromethylphenyl)-(RS)-alaninate (2l): beige powder, yield 0.261 g (61%); m.p. 79–80 °C; IR, ν, cm−1: 3004, 2955, 1738 (C=O), 1651 (C=O), 1612, 1587, 1488, 1462, 1441, 1383, 1325, 1300, 1255, 1205, 1205, 1166, 1116, 1088, 1067, 1045, 983; 1H NMR (400 MHz, DMSO-d6) δ 7.87 (br. s, 1H, CH Ar), 7.77–7.73 (m, 2H, H Ar), 7.63 (t, J = 7.7, 7.7 Hz, 1H, H Ar), 5.08 (q, J = 7.0 Hz, 1H, CH), 3.75 (s, 3H, OCH3), 1.35 (d, J = 7.0 Hz, 3H, CH3); 13C NMR (100 MHz, DMSO-d6) δ 170.9 (C=O), 159.0 (C=O), 155.8 (C Het), 146.1 (C Het), 138.9 (C Ar), 133.3 (CH Ar), 130.6 (CH Ar), 129.7 (q, JC-F = 32.3 Hz, p-C Ar), 126.2 (q, JC-F = 3.8 Hz, CH Ar), 125.9 (q, JC-F = 3.3 Hz, CH Ar), 123.4 (q, JC-F = 272.8 Hz, CF3), 119.9 (C Het), 56.2 (CH), 52.4 (OCH3), 14.7 (CH3); EI-MS m/z (%): 430 [M+4]+ (1), 429 [M+3]+ (1), 428 [M+2]+ (6), 427 [M+1]+ (2), 426 [M]+ (7), 407 (1), 395 [M–OCH3]+ (1), 379 (2), 369 [M+2–CO2CH3]+ (38), 368 [M+2–HCO2CH3]+ (10), 367 [M–CO2CH3]+ (56), 246 (7), 182 [HetCO+2]+ (69), 181 [HetCHO]+ (7), 180 [HetCO]+ (100), 145 (31), 125 (4), 110 (2). Analysis calculated for C15H11Cl2F3N2O3S (Mr = 427.22): C 42.17, H 2.60, N 6.56, S 7.50; found C 41.91, H 2.78, N 6.32, S 7.37%.
3.2. X-ray Structure Determination of 1f
Crystal data for C14H14ClN3O3S (M = 339.79 g/mol): orthorhombic, space group Pbca, a = 9.5344(12) Å, b = 13.538(2) Å, c = 23.985(3) Å, V = 3095.9(8) Å3, Z = 8, μ(MoKα) = 0.397 mm−1, Dcalc = 1.458 g/cm3, 11,607 reflections measured (7.3° ≤ 2Θ ≤ 60.976°), 4160 unique (Rint = 0.0662, Rsigma = 0.0850) were used in all calculations. The final R1 = 0.0766, wR2 = 0.2065 (I > 2σ(I)) and R1 = 0.1513, wR2 = 0.2655 (all data). Largest diff. peak/hole 0.30/−0.35 ēÅ−3.
The experiment was accomplished on the automated X-ray diffractometer «Xcalibur 3» with CCD detector following standard procedures (MoKα-irradiation, graphite monochromator, ω-scans with 1o step at T = 295(2) K). Empirical absorption correction was applied. The structure was solved using the intrinsic phases in ShelXT program [44] and refined by ShelXL [45] using full-matrix least-squared method for non-hydrogen atoms. The H-atoms were placed in the calculated positions and were refined in isotropic approximation. The solution and refinement of the structures were accomplished with the Olex program package [46]. Detailed parameters are shown in Table 5 [47]. The XRD data were deposited in the Cambridge Structural Database with number CCDC 2212217. These data can be requested free of charge via www.ccdc.cam.ac.uk.
Table 5.
Experimental details of the XRD study.
3.3. Fungicidal Activity In Vitro
The fungicidal activity of all the compounds was tested in vitro on Alternaria brassicicola (Schwein.) Wiltshire MFP240231, Alternaria solani Sorauer MFP601021, Botrytis cinerea Pers. MFG 60449, Colletotrichum coccodes JS 161-1, Fusarium solani (Mart.) Sacc. MFG 70523, Phytophthora infestans (Mont.) de Bary, Plenodomus lingam (Tode:Fr.) Höhn. MF Br17-044, Rhizoctonia solani RCAM01785 and Sclerotinia sclerotiorum, using the poisoned food technique. P. infestans was isolated in Nankai University (Tianjin, China). C. coccodes was purchased from the Russian National Collection of Industrial Microorganisms (Moscow, Russia). Other fungal strains were purchased from the Russian Collection of Agriculture Microorganisms (Saint-Petersburg, Russia).
The solutions of the compounds were prepared at a concentration of 1 mg/mL by dissolving 10 mg of the compound in 1 mL of DMSO, accompanied by an addition of 9 mL of water. A total of 1 mL of the tested solutions were added to Petri dishes containing 9 mL of the heated (60 °C) culture medium and homogeneously mixed in the laminar flow cabinet. Uniform fungal discs (4 mm diameter) were aseptically cut from a 7-day old culture of the test fungus using a sterile cork borer. Discs of mycelia were placed on the center of Petri dishes containing room temperature culture medium. The negative control was prepared with culture medium and DMSO only. Each compound and control treatments were in triplicate; the fungi were incubated at 25 °C (48 h for R. solani; 120 h for A. solani, A. brassicicola, P. lingam; 72 h for other fungi). The diameters of the fungal colonies were measured after incubation. Inhibition of the pathogen development was determined according to the formula of Royse and Ries [48]: I (%) = [(C − T)/(C − 4 mm)] × 100, where I (%) is the degree of inhibition of mycelial growth, T (mm) is the mean value of the diameter of the colonies in the presence of a given concentration of each compound and C (mm) is the mean diameter of the colonies in the absence of the compound under the same conditions. All the experiments were carried out in triplicate. The standard deviation was calculated.
3.4. Protective Activity of Compounds 1d and 2d on Rape Leaves
The in vivo protective activity of compounds 1d and 2d against A. brassicicola was evaluated at a concentration of 200 μg/mL, according to previously reported procedures [49]. Tiadinil and isotianil were chosen as positive controls. The negative control was sprayed with sterile water containing 0.1% of DMSO. Rape plants were grown in pots to the 5-leaf stage. Rape leaves were cut and sprayed with solution of test compound and placed in 10-mm sterile Petri dishes on 2 pieces of filter paper. Then, 5 mL of sterile water was added to maintain humidity. After 24 h, discs of mycelia were placed on each side of the leaf at an equal distance from the median vein. Inoculated leaves were placed at 25 °C with a daily 16-h light period and 80% humidity in the Binger climate chamber for disease development. After 5 days of inoculation, disease spot diameters were measured and protection efficacy was calculated according to the above formula [48]. All the experiments were carried out in triplicate. The standard deviation was calculated.
4. Conclusions
In total, 24 new heterocyclic derivatives of N-acyl-N-arylalaninates were synthesized. The structures of all target compounds were proven using 1H and 13C NMR spectroscopy, IR spectroscopy and mass spectrometry. In the series of obtained compounds, methyl N-acyl-N-arylalaninates exhibiting medium fungicidal activity against S. sclerotiorum were identified, two of which were also moderately active against B. cinerea and R. solani. Compound 1d was shown to exhibit high protective properties in vivo against A. brassicicola, suppressing the development of the disease on rapeseed leaves at a level similar to tiadinil.
Supplementary Materials
The following supporting information can be downloaded at: https://www.mdpi.com/article/10.3390/molecules28010419/s1, 1H, 13C NMR spectra for compounds 1a–l and 2a–l, 2D HMBS and HSQC spectra for compounds 1a, 2b, 2e and 2j (Figure S1–S57).
Author Contributions
Conceptualization, T.V.G.; methodology, Z.F.; investigation, T.A.K., V.I.B. (synthesis and spectral characterization, biological study) and P.A.S. (X-ray investigation); writing—original draft preparation, T.A.K., K.L.O. and T.V.G.; writing—review and editing, T.V.G. and V.A.B.; visualization, K.L.O.; supervision, T.V.G. All authors have read and agreed to the published version of the manuscript.
Funding
This research was supported by the Russian Science Foundation and Government of Sverdlovsk region, Joint Grant No 22-26-20124, https://rscf.ru/en/project/22-26-20124/ (accessed on 1 January 2023).
Institutional Review Board Statement
Not applicable.
Informed Consent Statement
Not applicable.
Data Availability Statement
Data are contained within the article and Supplementary Materials.
Acknowledgments
The authors are grateful to the Laboratory of Integrated Research and Expert Evaluation of Organic Materials of Ural Federal University for the registration of NMR spectra of compounds.
Conflicts of Interest
The authors declare no conflict of interest.
Sample Availability
Samples of the compounds 1a–l, 2a–l, 3a–l are available from the authors.
References
- Knogge, W. Fungal Infection of Plants. Plant Cell 1996, 8, 1711–1722. [Google Scholar] [CrossRef] [PubMed]
- Gonzalez-Fernandez, R.; Prats, E.; Jorrin-Novo, J.V. Proteomics of Plant Pathogenic Fungi. J. Biomed. Biotechnol. 2010, 2010, 932527. [Google Scholar] [CrossRef] [PubMed]
- Fisher, D.J.; Hayes, A.L. Mode of Action of the Systemic Fungicides Furalaxyl, Metalaxyl and Ofurace. Pestic. Sci. 1982, 13, 330–339. [Google Scholar] [CrossRef]
- Williams, A. Opportunities for chiral agrochemicals. Pestic. Sci. 1996, 46, 3–9. [Google Scholar] [CrossRef]
- Perez de Albuquerque, N.C.; Carrão, D.B.; Habenschus, M.D.; Moraes de Oliveira, A.R. Metabolism studies of chiral pesticides. J. Pharm. Biomed. Anal. 2018, 147, 89–109. [Google Scholar] [CrossRef]
- Sukul, P.; Spiteller, M. Metalaxyl: Persistence, degradation, metabolism, and analytical methods. Rev. Environ. Contam. Toxicol. 2000, 164, 1–26. [Google Scholar]
- Urech, P.A.; Staub, T. The resistance strategy for acylalanine fungicides. EPPO Bull. 1985, 15, 539–543. [Google Scholar] [CrossRef]
- Tripathi, D.; Raikhy, G.; Kumar, D. Chemical elicitors of systemic acquired resistance—Salicylic acid and its functional analogs. Curr. Plant Biol. 2019, 17, 48–59. [Google Scholar] [CrossRef]
- Ishii, H.; Tomita, Y.; Horio, T.; Narusaka, Y.; Nakazawa, Y.; Nishimura, K.; Iwamoto, S. Induced Resistance of Acibenzolar-S-methyl (CGA 245704) to Cucumber and Japanese Pear Diseases. Eur. J. Plant Pathol. 1999, 105, 77–85. [Google Scholar] [CrossRef]
- Zhang, S.; Reddy, M.S.; Kokalis-Burelle, N.; Wells, L.W.; Nightengale, S.P.; Kloepper, J.W. Lack of Induced Systemic Resistance in Peanut to Late Leaf Spot Disease by Plant Growth-Promoting Rhizobacteria and Chemical Elicitors. Plant Dis. 2001, 85, 879–884. [Google Scholar] [CrossRef]
- Sun, C.; Zhang, S.; Qian, P.; Li, Y.; Ren, W.; Deng, H.; Jiang, L. Synthesis and fungicidal activity of novel benzimidazole derivatives bearing pyrimidine-thioether moiety against Botrytis cinerea. Pest Manag. Sci. 2021, 77, 5529–5536. [Google Scholar] [CrossRef] [PubMed]
- Chen, L.; Zhao, B.; Fan, Z.; Hu, M.; Li, Q.; Hu, W.; Li, J.; Zhang, J. Discovery of Novel Isothiazole, 1,2,3-Thiadiazole, and Thiazole-Based Cinnamamides as Fungicidal Candidates. J. Agric. Food Chem. 2019, 67, 12357–12365. [Google Scholar] [CrossRef] [PubMed]
- Wu, Q.-F.; Zhao, B.; Fan, Z.-J.; Zhao, J.-B.; Guo, X.-F.; Yang, D.-Y.; Zhang, N.-L.; Yu, B.; Kalinina, T.; Glukhareva, T. Design, synthesis and fungicidal activity of isothiazole–thiazole derivatives. RSC Adv. 2018, 8, 39593–39601. [Google Scholar] [CrossRef] [PubMed]
- Chen, Y.-C.; Kuo, Y.-T.; Ho, T.-H. Photo-polymerization properties of type-II photoinitiator systems based on 2-chlorohexaaryl biimidazole (o-Cl-HABI) and various N-phenylglycine (NPG) derivatives. Photochem. Photobiol. Sci. 2019, 18, 190–197. [Google Scholar] [CrossRef]
- Ozcan, S.; Kazi, A.; Marsilio, F.; Fang, B.; Guida, W.C.; Koomen, J.; Lawrence, H.R.; Sebti, S.M. Oxadiazole-isopropylamides as Potent and Noncovalent Proteasome Inhibitors. J. Med. Chem. 2013, 56, 3783–3805. [Google Scholar] [CrossRef]
- Specklin, S.; Decuypere, E.; Plougastel, L.; Aliani, S.; Taran, F. One-Pot Synthesis of 1,4-Disubstituted Pyrazoles from Arylglycines via Copper-Catalyzed Sydnone–Alkyne Cycloaddition Reaction. J. Org. Chem. 2014, 79, 7772–7777. [Google Scholar] [CrossRef]
- Dai, L.-L.; Zhang, H.-Z.; Nagarajan, S.; Rasheed, S.; Zhou, C.-H. Synthesis of tetrazole compounds as a novel type of potential antimicrobial agents and their synergistic effects with clinical drugs and interactions with calf thymus DNA. MedChemComm 2015, 6, 147–154. [Google Scholar] [CrossRef]
- Pei, M.; Kong, H.; Tian, A.; Liu, X.; Zheng, K.; Ren, Z.; Wang, L. Novel benzotriazole-based probes for the selective detection of Cu(II). J. Mol. Struct. 2022, 1250, 131806. [Google Scholar] [CrossRef]
- da Silva Mesquita, R.; Kyrylchuk, A.; Grafova, I.; Kliukovskyi, D.; Bezdudnyy, A.; Rozhenko, A.; Tadei, W.P.; Leskelä, M.; Grafov, A. Synthesis, molecular docking studies, and larvicidal activity evaluation of new fluorinated neonicotinoids against Anopheles darlingi larvae. PLoS ONE 2020, 15, E0227811. [Google Scholar] [CrossRef]
- Li, Z.; Liu, C.; Yang, J.; Zhou, J.; Ye, Z.; Feng, D.; Yue, N.; Tong, J.; Huang, W.; Qian, H. Design, synthesis and biological evaluation of novel FFA1/GPR40 agonists: New breakthrough in an old scaffold. Eur. J. Med. Chem. 2019, 179, 608–622. [Google Scholar] [CrossRef]
- Sun, Y.-X.; Song, J.; Kong, L.-J.; Sha, B.-B.; Tian, X.-Y.; Liu, X.-J.; Hu, T.; Chen, P.; Zhang, S.-Y. Design, synthesis and evaluation of novel bis-substituted aromatic amide dithiocarbamate derivatives as colchicine site tubulin polymerization inhibitors with potent anticancer activities. Eur. J. Med. Chem. 2022, 229, 114069. [Google Scholar] [CrossRef]
- Song, J.; Gao, Q.-L.; Wu, B.-W.; Li, D.; Shi, L.; Zhu, T.; Lou, J.-F.; Jin, C.-Y.; Zhang, Y.-B.; Zhang, S.-Y.; et al. Novel tertiary sulfonamide derivatives containing benzimidazole moiety as potent anti-gastric cancer agents: Design, synthesis and SAR studies. Eur. J. Med. Chem. 2019, 183, 111731. [Google Scholar] [CrossRef]
- Evano, G.; Nitelet, A.; Thilmany, P.; Dewez, D.F. Metal-mediated halogen exchange in aryl and vinyl halides: A review. Front. Chem. 2018, 6, 114. [Google Scholar] [CrossRef]
- Okamoto, I.; Terashima, M.; Masu, H.; Nabeta, M.; Ono, K.; Morita, N.; Katagiri, K.; Azumaya, I.; Tamura, O. 836687: Experimental Crystal Structure Determination; Cambridge Crystallographic Data Centre: Cambridge, UK, 2011. [Google Scholar] [CrossRef]
- Okamoto, I.; Terashima, M.; Masu, H.; Nabeta, M.; Ono, K.; Morita, N.; Katagiri, K.; Azumaya, I.; Tamura, O. CCDC 836686: Experimental Crystal Structure Determination; Cambridge Crystallographic Data Centre: Cambridge, UK, 2011. [Google Scholar] [CrossRef]
- Okamoto, I.; Terashima, M.; Masu, H.; Nabeta, M.; Ono, K.; Morita, N.; Katagiri, K.; Azumaya, I.; Tamura, O. CCDC 836688: Experimental Crystal Structure Determination; Cambridge Crystallographic Data Centre: Cambridge, UK, 2011. [Google Scholar] [CrossRef]
- Okamoto, I.; Nabeta, M.; Minami, T.; Nakashima, A.; Morita, N.; Takeya, T.; Masu, H.; Azumaya, I.; Tamura, O. CCDC 625148: Experimental Crystal Structure Determination; Cambridge Crystallographic Data Centre: Cambridge, UK, 2007. [Google Scholar] [CrossRef]
- Okamoto, I.; Nabeta, M.; Minami, T.; Nakashima, A.; Morita, N.; Takeya, T.; Masu, H.; Azumaya, I.; Tamura, O. CCDC 625149: Experimental Crystal Structure Determination; Cambridge Crystallographic Data Centre: Cambridge, UK, 2007. [Google Scholar] [CrossRef]
- Okamoto, I.; Nabeta, M.; Minami, T.; Nakashima, A.; Morita, N.; Takeya, T.; Masu, H.; Azumaya, I.; Tamura, O. CCDC 625150: Experimental Crystal Structure Determination; Cambridge Crystallographic Data Centre: Cambridge, UK, 2007. [Google Scholar] [CrossRef]
- Okamoto, I.; Nabeta, M.; Minami, T.; Nakashima, A.; Morita, N.; Takeya, T.; Masu, H.; Azumaya, I.; Tamura, O. CCDC 625151: Experimental Crystal Structure Determination; Cambridge Crystallographic Data Centre: Cambridge, UK, 2007. [Google Scholar] [CrossRef]
- Okamoto, I.; Nabeta, M.; Minami, T.; Nakashima, A.; Morita, N.; Takeya, T.; Masu, H.; Azumaya, I.; Tamura, O. CCDC 625152: Experimental Crystal Structure Determination; Cambridge Crystallographic Data Centre: Cambridge, UK, 2007. [Google Scholar] [CrossRef]
- Okamoto, I.; Terashima, M.; Masu, H.; Nabeta, M.; Ono, K.; Morita, N.; Katagiri, K.; Azumaya, I.; Tamura, O. CCDC 836680: Experimental Crystal Structure Determination; Cambridge Crystallographic Data Centre: Cambridge, UK, 2011. [Google Scholar] [CrossRef]
- Okamoto, I.; Terashima, M.; Masu, H.; Nabeta, M.; Ono, K.; Morita, N.; Katagiri, K.; Azumaya, I.; Tamura, O. CCDC 836681: Experimental Crystal Structure Determination; Cambridge Crystallographic Data Centre: Cambridge, UK, 2011. [Google Scholar] [CrossRef]
- Okamoto, I.; Terashima, M.; Masu, H.; Nabeta, M.; Ono, K.; Morita, N.; Katagiri, K.; Azumaya, I.; Tamura, O. CCDC 836682: Experimental Crystal Structure Determination; Cambridge Crystallographic Data Centre: Cambridge, UK, 2011. [Google Scholar] [CrossRef]
- Okamoto, I.; Terashima, M.; Masu, H.; Nabeta, M.; Ono, K.; Morita, N.; Katagiri, K.; Azumaya, I.; Tamura, O. Acid-induced conformational alteration of cis-preferential aromatic amides bearing N-methyl-N-(2-pyridyl) moiety. Tetrahedron 2011, 67, 8536–8543. [Google Scholar] [CrossRef]
- Okamoto, I.; Terashima, M.; Masu, H.; Nabeta, M.; Ono, K.; Morita, N.; Katagiri, K.; Azumaya, I.; Tamura, O. CCDC 836684: Experimental Crystal Structure Determination; Cambridge Crystallographic Data Centre: Cambridge, UK, 2011. [Google Scholar] [CrossRef]
- Okamoto, I.; Terashima, M.; Masu, H.; Nabeta, M.; Ono, K.; Morita, N.; Katagiri, K.; Azumaya, I.; Tamura, O. CCDC 836685: Experimental Crystal Structure Determination; Cambridge Crystallographic Data Centre: Cambridge, UK, 2011. [Google Scholar] [CrossRef]
- Obydennov, K.L.; Kalinina, T.A.; Galieva, N.A.; Beryozkina, T.V.; Zhang, Y.; Fan, Z.; Glukhareva, T.V.; Bakulev, V.A. Synthesis, Fungicidal Activity, and Molecular Docking of 2 Acylamino and 2 Thioacylamino Derivatives of 1H benzo[d]imidazoles as Anti-Tubulin Agents. J. Agric. Food Chem. 2021, 69, 12048–12062. [Google Scholar] [CrossRef]
- Fache, F.; Valot, F.; Milenkovic, A.; Lemaire, M. Catalytic reductive N-alkylation of anilines. Application to the synthesis of N-aryl aminoacid precursors. Tetrahedron 1996, 52, 9777–9784. [Google Scholar] [CrossRef]
- Zhao, F.; Yang, Q.; Zhang, J.; Shi, W.; Hu, H.; Liang, F.; Wei, W.; Zhou, S. Photocatalytic Hydrogen-Evolving Cross-Coupling of Arenes with Primary Amines. Org. Lett. 2018, 20, 7753–7757. [Google Scholar] [CrossRef]
- Taylor, J.E.; Daniels, D.S.B.; Smith, A.D. Asymmetric NHC-Catalyzed Redox α-Amination of α-Aroyloxyaldehydes. Org. Lett. 2013, 15, 6058–6061. [Google Scholar] [CrossRef]
- Elisi, G.M.; Bedini, A.; Scalvini, L.; Carmi, C.; Bartolucci, S.; Lucini, V.; Scaglione, F.; Mor, M.; Rivara, S.; Spadoni, G. Chiral Recognition of Flexible Melatonin Receptor Ligands Induced by Conformational Equilibria. Molecules 2020, 25, 4057. [Google Scholar] [CrossRef]
- Guo, W.; Li, P.; Luo, Y.; Sun, J.; Sung, H.H.-Y.; Williams, I.D. Chiral Phosphoric Acid Catalyzed Enantioselective Synthesis of α-Tertiary Amino Ketones from Sulfonium Ylides. J. Am. Chem. Soc. 2020, 142, 14384–14390. [Google Scholar] [CrossRef]
- Sheldrick, G.M. SHELXT—Integrated space-group and crystal-structure determination. Acta Crystallogr. A Found. Adv. 2015, 71, 3–8. [Google Scholar] [CrossRef]
- Sheldrick, G.M. Crystal structure refinement with SHELXL. Acta Crystallogr. C Struct. Chem. 2015, 71, 3–8. [Google Scholar] [CrossRef]
- Dolomanov, O.V.; Bourhis, L.J.; Gildea, R.J.; Howard, J.A.K.; Puschmann, H. OLEX2: A Complete Structure Solution, Refinement and Analysis Program. J. Appl. Cryst. 2009, 42, 339–341. [Google Scholar] [CrossRef]
- Westrip, S.P. publCIF: Software for editing, validating and formatting crystallographic information files. J. Appl. Crystallogr. 2010, 43, 920–925. [Google Scholar] [CrossRef]
- Royse, D.J.; Ries, S.M. The influence of fungi isolated from peach twigs on the pathogenicity of Cytospora cincta. Phytopathology 1978, 68, 603–607. [Google Scholar] [CrossRef]
- Gong, Y.; Fu, Y.; Xie, J.; Li, B.; Chen, T.; Lin, Y.; Chen, W.; Jiang, D.; Cheng, J. Sclerotinia sclerotiorum SsCut1 Modulates Virulence and Cutinase Activity. J. Fungi 2022, 8, 526. [Google Scholar] [CrossRef]
Disclaimer/Publisher’s Note: The statements, opinions and data contained in all publications are solely those of the individual author(s) and contributor(s) and not of MDPI and/or the editor(s). MDPI and/or the editor(s) disclaim responsibility for any injury to people or property resulting from any ideas, methods, instructions or products referred to in the content. |
© 2023 by the authors. Licensee MDPI, Basel, Switzerland. This article is an open access article distributed under the terms and conditions of the Creative Commons Attribution (CC BY) license (https://creativecommons.org/licenses/by/4.0/).